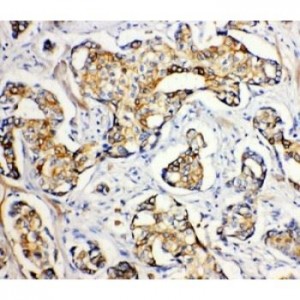
SERCA2 ATPase Antibody

Immunohistochemistry (IHC)
Showing 205–216 of 1068 resultsSorted by latest
-

Serum Amyloid P Antibody
$365.00 Add to cart -

Serum Amyloid P Antibody
$365.00 Add to cart -

SerpinB2 Antibody
$365.00 Add to cart -

SERPINA1 Antibody
$365.00 Add to cart -

Serotonin transporter Antibody
$330.00 Add to cart -
SERCA2 ATPase Antibody
$330.00 Add to cart -

SERCA1 ATPase Antibody
$330.00 Add to cart -

Selenium Binding Protein 1 Antibody
$330.00 Add to cart -

Secretogranin 3 Antibody
$330.00 Add to cart -

SDHC Antibody
$330.00 Add to cart -

SDHB Antibody
$330.00 Add to cart -

SDHA Antibody
$330.00 Add to cart